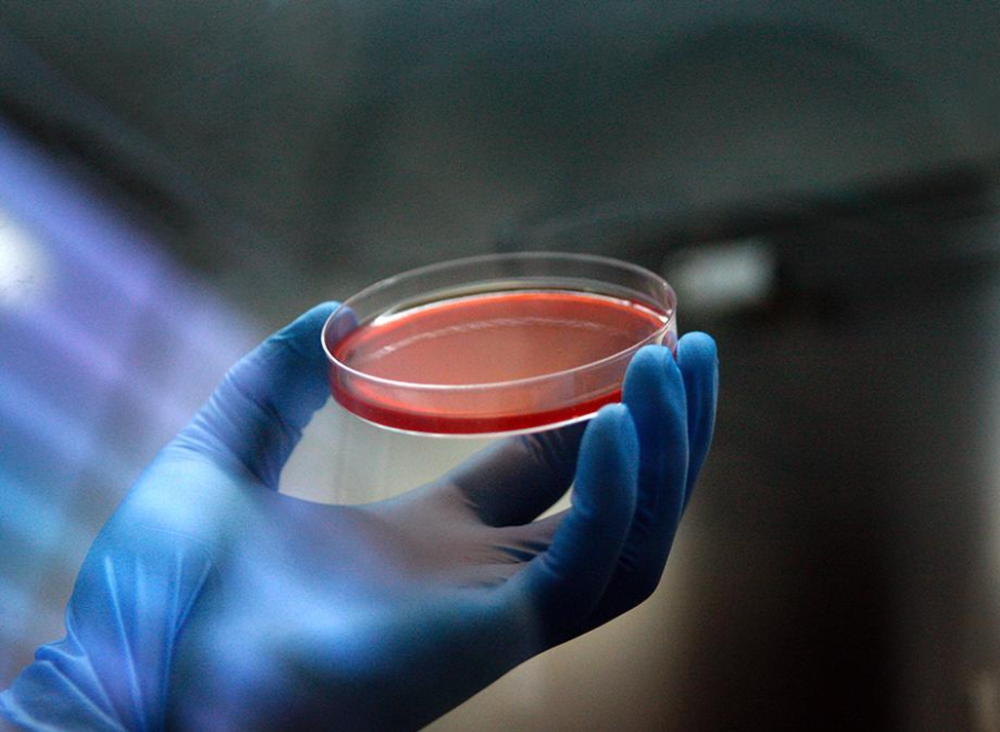
La mayoría de los pacientes diagnosticados de cáncer a la vesícula, incluso aquellos que se someten a cirugías, progresa rápidamente a un estado metastásico altamente resistente a la quimioterapia convencional.

Un estudio con 243 pacientes chilenos en la Región de Los Ríos identificó una combinación de tres marcadores genéticos que se asocian a una mayor sobrevida de pacientes con esta enfermedad, que registra una alta prevalencia en América Latina y Asia por razones étnicas y socioculturales. De hecho, Chile tiene la incidencia y mortalidad más alta del mundo, sobre todo en regiones del sur del país, afectando principalmente a mujeres de mediana edad.
El hallazgo, publicado por la revista Cancers (ubicada en el primer cuartil de impacto), fue posible gracias al uso de herramientas computacionales avanzadas y la amplia casuística acumulada en los últimos veinte años por el Hospital Base de Valdivia, desde donde se extrajeron las muestras y datos que fueron utilizados para esta investigación. El trabajo, financiado con fondos del Gobierno Regional de Los Ríos, fue liderado por el Dr. Flavio Salazar, académico de la Facultad de Medicina de la Universidad de Chile, en colaboración con la Dra. Claudia Quezada, de la Universidad Austral, y médicos del Hospital Base de Valdivia.
Los investigadores plantean que los resultados de la investigación representan un primer paso que, sin embargo, requiere de nuevas exploraciones en próximos estudios. “El cáncer de vesícula biliar es una patología altamente prevalente en Chile, mucho más que en el resto del mundo, con la mayor concentración de casos en Valdivia. Esto se podría relacionar con aspectos genéticos, debido a su alta prevalencia en la población mapuche, pero también con factores socioculturales, como la alimentación, la calidad de vida y la microbiota, entre otros. Hemos analizado muestras de tumores desde el año 1995 hasta el 2019, y estudiado en paralelo la información de fichas clínicas de los pacientes”, explica el profesor Flavio Salazar.
La Dra. Quezada, en tanto, destacó el propósito de la iniciativa respecto a la exploración de un problema de salud pública especialmente complejo en Chile, en la zona donde este es más crítico: la Región de Los Ríos. Y aunque la plataforma de pronóstico basado en marcadores necesita ser validada, contar con una herramienta para el diagnóstico y pronóstico del cáncer puede tener una alta utilidad para la salud pública local. “Son hitos importantes que han motivado la adjudicación de dos proyectos FIC por parte del Gobierno Regional”, afirma la especialista.
Pronósticos de sobrevida
El cáncer de vesícula biliar es un carcinoma del tracto biliar altamente agresivo y fatal. Su incidencia varía ampliamente, con los casos más altos informados anualmente en algunas regiones de Europa del Este, Asia y América Latina. En Chile, la mayor parte de los casos se dan en la zona sur. A menudo, la condición se diagnostica en etapas avanzadas debido a síntomas clínicos inespecíficos, lo que hace que menos del 10% de los pacientes sean candidatos para la resección quirúrgica. Su tasa de supervivencia a cinco años oscila entre el 4 y el 60%, dependiendo principalmente del estadio de la enfermedad en el momento de la detección. En casos que se encuentran en etapas avanzadas, el tiempo de sobrevida promedio va de los cuatro a los 14 meses.
La mayoría de los pacientes diagnosticados, incluso aquellos que se someten a cirugías, progresa rápidamente a un estado metastásico altamente resistente a la quimioterapia convencional. Aunque la terapia sistémica paliativa y la cirugía combinadas con quimioterapia adyuvante son actualmente las mejores opciones para mejorar los resultados clínicos, no han sido suficientes para aumentar significativamente las tasas de supervivencia de los pacientes.
En este contexto, la inmunoterapia puede ser una herramienta importante en el tratamiento de esta enfermedad a futuro, por lo que resulta necesario estudiar la relación del sistema inmune y este tipo específico de tumor, plantea el profesor Flavio Salazar. El trabajo del investigador de la U. de Chile en los últimos 20 años ha contribuido al desarrollo de dos vacunas contra el cáncer, una de ellas contra el cáncer de vesícula biliar, y que actualmente se proyecta ser probada en un ensayo clínico de fase 1 en Chile. Dichas soluciones biotecnológicas son actualmente transferidas al mercado por la startup Oncobiomed, un spinoff de la Universidad de Chile que posee la licencia para la explotación de estas tecnologías.
La reciente publicación advierte que, en este contexto, una de las principales causas de resistencia a los tratamientos radica en las condiciones de base del sistema inmunológico y en la sobreexpresión de proteínas asociadas a la tolerancia a múltiples fármacos en las células cancerosas. “Lo que hicimos fue identificar con tinción de tejidos automatizada y métodos computacionales avanzados una serie de marcadores asociados a la sobrevida de los pacientes, a su respuesta inmune contra los tumores y a la resistencia a tratamientos”, precisa el Dr. Salazar.
En esta línea, identificó que la presencia de esta asociación de tres marcadores genéticos expresados en las células cancerígenas podría predecir el comportamiento de la enfermedad, suministrando información para una mejor toma de decisiones por parte de los equipos clínicos. La Dra. Quezada explica que esto, además, ha permitido avanzar hacia el desarrollo de un software capaz de detectar marcadores y, de esta forma, generar pronósticos para un mejor tratamiento.
“Este software permite analizar alrededor 18 marcadores para cáncer de vesícula biliar e identificar un pequeño grupo de tres de ellos que se relacionan fuertemente con la evolución clínica de una enfermedad sobre la que hay poca información a nivel mundial. Por eso, creemos que este software permitirá hacer seguimiento de los pacientes y predecir tratamientos, tanto de quimioterapia como de inmunoterapia útiles para el diagnóstico y pronóstico”, señala la investigadora.
“Estos hallazgos se tienen que corroborar con nuevos estudios en un nuevo cohorte de pacientes para su confirmación, y podrían permitir hacer un monitoreo más preciso de la evolución de la enfermedad en el futuro. Es una forma de obtener información previa para hacer pronósticos o generar un programa computacional que calcule proyecciones en cada caso, sugiriendo la aplicación de tratamientos más o menos intensivos”, complementa el profesor Flavio Salazar.
En otras palabras, si el paciente posee estos marcadores (proteínas presentes en las células tumorales) que indican que la enfermedad puede progresar más lento, la decisión sería hacer un tratamiento menos agresivo y de seguimiento más largo, lo que permite ahorrar recursos y aumentar la eficiencia en el uso de estos, canalizándolos a los pacientes más susceptibles de progresar en la enfermedad. El valor, expresó el actual asesor científico de Oncobiomed, radica en incorporar nuevos conocimientos a la escasa evidencia que se tiene sobre este cáncer.
“El cáncer de vesícula biliar es una patología oncológica poco estudiada a nivel mundial por su baja incidencia en los países industrializados de occidente, aunque en el caso de Chile tiene una alta relevancia de salud pública. Dentro de la comunidad científica nacional, este artículo nos pone en la vanguardia del conocimiento y de la búsqueda, a través de metodología de punta, de marcadores con impacto en el pronóstico, diagnóstico y tratamiento del cáncer”, señala el académico.
Crear metodologías avanzadas
Los análisis de las muestras se realizaron con programas basados en inteligencia artificial. Antes de esto, las muestras se observan en el microscopio por patólogos especialistas y luego se digitalizan para así explorar en profundidad células individuales, marcadores y expresión de los mismos utilizando programas de análisis de imágenes. Estos datos se cruzaron con todas las características de los pacientes: sexo, edad, cirugía o tratamiento, y la etapa de la enfermedad, entre otros. Luego, con el apoyo de analistas informáticos de la Universidad Tecnológica Metropolitana y de la Universidad de Concepción, se buscaron correlaciones estadísticas que terminaron con el hallazgo de los tres marcadores en los tejidos extraídos de los tumores (MRP2, CXCR4, and PD-L1), los que tendrían relación con el tiempo en que los pacientes se mantienen con vida.
La investigación exploró información de 243 pacientes, una casuística que los científicos involucrados definen como “importante”. Además de las muestras de tejidos tumorales, también se observaron las fichas clínicas de los individuos. La metodología se denomina como “inmunohistoquímica automatizada”, y se ubica en los laboratorios de la Unidad de Patología del Hospital Base de Valdivia. Sus capacidades permiten explorar cientos de posibles marcadores en pequeñas muestras y medir parámetros en forma rápida y eficiente. También se utilizaron programas computacionales para el escáner de muestras de tejidos microscópicos con un profundo nivel de detalle, con lo cual no solamente se puede ver si el marcador es positivo o negativo, sino también su ubicación, la morfología de la célula, qué tipo de células se expresan en un marcador y, finalmente, poner estos parámetros en una base de datos.
De acuerdo al académico de la Universidad de Chile, esto ha posibilitado la obtención de resultados de mayor impacto, al agrupar parámetros altamente complejos, con una gran cantidad de marcadores y su asociación con aspectos clínicos como la sobrevida. De hecho, para el ex ministro de Ciencia, uno de los aspectos interesantes de este proyecto es el uso de herramientas tecnológicas avanzadas, presentes en Chile y gestionadas por capital humano local, realizada mediante la colaboración de distintas instituciones de la capital y de las regiones, lo que transforma este trabajo en un proyecto de impacto nacional.
“Con estas metodologías avanzadas, originales, hemos logrado como resultado identificar marcadores que pueden estar relacionados con la respuesta de los pacientes en cáncer de vesícula biliar. Sin duda, esto puede tener un impacto en el futuro para el desarrollo de nuevas herramientas, para lo cual estamos tomando nuevas muestras que nos permitan reproducir esta asociación de marcadores y generar un software de uso clínico para el pronóstico”, afirma el Dr. Flavio Salazar.
“En definitiva, se genera una solución que tendría un valor de transferencia tecnológica, y que será útil para la medicina clínica, beneficiando a miles de pacientes en regiones, si logramos confirmar estos hallazgos en estudios posteriores”, comenta el académico de la Universidad de Chile y asesor de Oncobiomed.
Colaboración de larga data
En el trabajo tomaron parte varias instituciones médicas y científicas del país, en distintas regiones, entre ellas, las universidades de Chile, Austral, Tecnológica Metropolitana y de Concepción, además del Hospital Base de Valdivia y el Instituto Milenio de Inmunología e Inmunoterapia (IMII). A nivel internacional, en tanto, se sumaron investigadoras del Instituto Karolinska, de Suecia, que realizaron una pasantía en Chile. El proyecto fue financiado por el Gobierno Regional de Los Ríos y podría seguir recibiendo respaldo público para nuevos desarrollos.
“Lo que se destaca de este reporte es el trabajo conjunto y la colaboración entre diversas instituciones públicas y de la academia, lo que nos ha permitido estudiar en profundidad un problema de alto impacto para la salud pública, como es el cáncer de vesícula biliar en Chile y particularmente en la zona sur del país”, plantea la Dra. Quezada.
“Esto refleja que para poder resolver problemas locales tenemos que poner capacidades en conjunto y proyectarlas al ámbito global”, concluye el Dr. Salazar, quien destaca que en este trabajo hay una estrategia de colaboración interinstitucional desde hace más de diez años, cuyo objetivo es profundizar la comprensión de un problema de salud pública de enorme impacto en Chile, y que -a diferencia de otras enfermedades neoplásicas- tiene una baja incidencia en las grandes potencias biotecnológicas, lo que ha retrasado su estudio.